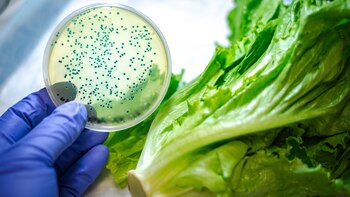
La supervisión de los productos

En un país donde la agricultura es el sustento de millones de personas y el motor de las exportaciones agroalimentarias, emerge un desafío silencioso pero cada vez más urgente: los residuos agroquímicos en los cultivos. Aunque Perú se ha consolidado como un actor clave en los mercados internacionales con productos como la quinua, fresas, los espárragos y el café, en el ámbito interno persiste un problema que amenaza tanto la salud pública como la reputación del país. ¿Qué se esconde realmente en los alimentos que llegan a las mesas de las familias peruanas?
Un estudio titulado “Presencia de pesticidas prohibidos a nivel internacional en quinua peruana durante la pandemia de COVID-19″ puso sobre la mesa una realidad alarmante. Investigadores de la Universidad del Pacífico y la Universidad Nacional Mayor de San Marcos evaluaron 27 paquetes de quinua blanca adquiridos en supermercados y tiendas orgánicas de Lima. Los resultados arrojaron que 20 de ellos contenían clorpirifos, un pesticida relacionado con problemas de desarrollo cognitivo en niños. Aunque este químico fue vetado en la Unión Europea en 2020, su prohibición en Perú recién se estableció en agosto de 2024.
En 2014, embarcaciones con quinua peruana fueron rechazadas en Estados Unidos debido a residuos de pesticidas que excedían los límites permitidos. Estos productos, en lugar de ser descartados, fueron redirigidos al mercado interno.
Angie Higuchi, profesora y miembro del Centro de Investigación de la Universidad del Pacífico, señaló para Infobae Perú que los exportadores están obligados a cumplir normativas internacionales, lo que implica pruebas de laboratorio en los productos antes de ser enviados. “La regulación debería ser igual de estricta para los productos destinados al consumo nacional. Si los exportadores pueden cumplir con estas normativas para los mercados extranjeros, ¿por qué no hacerlo aquí?”, cuestionó.
Leyes insuficientes y responsabilidades diluidas
Jaime Delgado, coordinador del monitoreo ciudadano sobre presencia de agroquímicos en los alimentos, encendió las alarmas en una entrevista reciente con Infobae Perú. Durante el tercer monitoreo realizado a nivel nacional, se identificó la presencia de clorpirifos, un pesticida prohibido debido a su alta toxicidad. Este compuesto, clasificado como interruptor endocrino, representa una amenaza significativa, especialmente para adolescentes en etapa de desarrollo hormonal. El experto advirtió que su consumo puede alterar el desarrollo sexual, reducir la capacidad reproductiva y, en algunos casos, anularla.
El sistema actual, según el abogado, presenta fallas estructurales que dificultan la supervisión efectiva de los alimentos. Si bien existe un marco normativo que establece límites máximos de residuos químicos, las leyes peruanas son mucho más permisivas que las europeas. Los agroexportadores cumplen con estándares internacionales estrictos, pero los alimentos destinados al consumo local carecen de la misma rigurosidad.
La Ley de Inocuidad de los Alimentos, que asigna al Servicio Nacional de Sanidad Agraria (Senasa) el rol de órgano rector, delega la fiscalización de los mercados locales a las municipalidades. Sin embargo, el experto indicó que las más de 1.800 municipalidades del país no cuentan con los recursos, ni la experiencia, ni el interés necesario para cumplir esta tarea. “No existe una autoridad central que garantice la inocuidad de los productos que llegan al mercado interno. Esto es tierra de nadie”, afirmó.
Además, señaló que el Ministerio Público comezó a abrir carpetas fiscales por prevención del delito tras ser informado sobre la gravedad del problema. Aunque esto podría marcar un inicio, Jaime Delgado insiste en que se necesita una reforma estructural para crear una sola autoridad sanitaria nacional que unifique las competencias y responsabilidades.
La necesidad de mayor control municipal

El excongresista especializado en derechos del consumidor, apuntó a la falta de control en los mercados locales como una de las causas principales del problema. “Son los alcaldes quienes deben realizar el control, pero muchos ni siquiera están al tanto de esta problemática. Nos hemos reunido con el Senasa, visitado sus laboratorios y tenemos reuniones pendientes. Incluso hemos dialogado con el ministro de Agricultura, quien es consciente de la necesidad de una reforma institucional. Sin esta reforma, nada va a cambiar. Sin embargo, esta es una tarea que nos involucra a todos.”
Según el ingeniero Rubén Carrasco, director ejecutivo de CultiVida, en declaraciones a Infobae Perú, señaló esta responsabilidad recae en los municipios, que muchas veces desconocen sus obligaciones en materia de inocuidad alimentaria. “Cada municipio debería contar con especialistas que realicen monitoreos frecuentes. Senasa hace su trabajo, pero no puede abarcar todo el país con los recursos disponibles. Es necesario un trabajo coordinado entre instituciones”, añadió el director ejecutivo de CultiVida.
En el Perú, la falta de control sobre la inocuidad de los alimentos en los mercados locales continúa siendo una problemática crítica. Según el experto, “ninguna autoridad del país hace control de inocuidad de los productos cuando entran al mercado local. Ninguna. Nunca lo han hecho”. Aunque el Senasa realiza monitoreos anuales, estos solo revelan niveles de contaminación ya consumida. “Eso es para saber cuánto veneno hemos consumido el año pasado. Pero no sirve para impedir que el producto ingrese al mercado”, añadió, destacando la necesidad urgente de reforzar los controles preventivos para proteger la salud de los consumidores.
Tres niveles de agricultura y una problemática compleja

La informalidad es uno de los factores clave que fomentan el mal uso de agroquímicos en el Perú, afirmó el ingeniero Rubén Carrasco. El país presenta tres tipos de agricultura: la moderna, caracterizada por el uso de tecnología avanzada y buenas prácticas; la mediana-emergente; y la de subsistencia, que concentra las mayores dificultades en el manejo adecuado de estos químicos.
El problema no se limita a los alimentos convencionales. Incluso productos etiquetados como orgánicos, como la quinua o el café, han presentado residuos de pesticidas en algunos casos, tal como señaló Angie Higuchi. Rubén Carrasco indicó que el Senasa, responsable de certificar estos alimentos, debe implementar controles más rigurosos para asegurar que los productos orgánicos cumplan con las normativas establecidas.
Frente a esta situación, Delgado propuso medidas concretas y masivas. “Necesitamos un sistema de fiscalización eficiente que garantice que todos los productos que ingresen al mercado sean aptos para el consumo humano. Esto requiere recursos económicos suficientes y un enfoque integral que involucre a todos los sectores: el Estado, los municipios, los supermercados y los propios agricultores”, enfatizó.
El rol de Senasa y el futuro de la inocuidad alimentaria

Desde su creación, el Senasa ha llevado a cabo planes de monitoreo anuales para analizar residuos químicos en alimentos agropecuarios. Según Hugo Contreras, especialista del Senasa, en 2023 se realizaron cerca de 8.500 muestras, de las cuales el 11% resultaron no conformes. Aunque esta cifra representa una mejora frente al 40% registrado en 2011, todavía queda mucho por hacer.
La falta de un sistema de fiscalización robusto y coordinado sigue siendo el mayor desafío. Aunque en el Congreso se discute un proyecto de ley para reformar el Senasa y centralizar las competencias, la implementación de estas reformas podría tardar años. Mientras tanto, los consumidores continúan expuestos a alimentos con niveles de residuos químicos que superan los límites permitidos.
El panorama actual refleja un sistema dividido entre la exportación, donde los estándares son elevados, y el consumo interno, donde las deficiencias son evidentes. Tanto Delgado como Carrasco coinciden en que se necesita una transformación profunda para garantizar la inocuidad de los alimentos en todos los niveles. Sin embargo, lograr un cambio real requerirá un compromiso colectivo que integre esfuerzos públicos, privados y comunitarios.
Impacto en la imagen del Perú a nivel internacional
La percepción internacional del Perú como exportador de alimentos de calidad se ve afectada por la informalidad en el manejo de agroquímicos. Carrasco indica que, aunque los problemas deberían tratarse internamente, la información trasciende las fronteras. Esto podría comprometer la posición de los productos peruanos en mercados exigentes, donde la inocuidad alimentaria es un requisito indispensable.
En otros países, mencionó el ingeniero, los mercados utilizan análisis rápidos para verificar los niveles de residuos en productos agrícolas antes de comercializarlos. Implementar esta práctica en el Perú requeriría un esfuerzo conjunto entre el Estado, los municipios y el sector privado.
Salud pública y medio ambiente
Los efectos de los pesticidas trascienden el ámbito alimentario. Investigaciones han relacionado estos químicos con problemas de salud graves, como cáncer, problemas endocrinos y defectos de nacimiento. Los pesticidas más tóxicos, aquellos más baratos y de mayor acceso para los agricultores, tienden a permanecer en el medio ambiente y acumularse en el cuerpo humano, amplificando los riesgos.
Para Matilde Schwalb, investigadora del Centro de Ética y Gestión Sostenible de la Universidad del Pacífico, el problema también radica en la falta de información para los consumidores. “Nadie sabe realmente lo que está comiendo. Se paga más por un producto que dice ser orgánico, pero sin controles adecuados, esa etiqueta no tiene valor”, sostuvo.
Además, hizo énfasis en que el incentivo para usar pesticidas baratos y tóxicos está vinculado a su bajo costo, lo que termina afectando tanto al medio ambiente como a la salud pública.
El panorama exige medidas integrales que incluyan la educación a los agricultores, el fortalecimiento de las capacidades de los municipios y un control más riguroso sobre los alimentos que llegan al consumidor final. En un país con tanta diversidad agrícola, el desafío no solo afecta a los pequeños productores, sino también a la imagen de una nación que depende del campo para alimentar tanto a su población como a mercados extranjeros.
Más Noticias
Dónde ver el sorteo del Mundial 2026 HOY en Perú: canal tv online del evento FIFA de selecciones
La máxima autoridad del fútbol global difundió la información referente al sorteo que definirá los enfrentamientos iniciales entre las cuarenta y ocho selecciones clasificadas

Campaña veterinaria gratuita para este 13 de diciembre: conoce dónde y cuáles son los servicios disponibles
El objetivo de esta propuesta es asegurar la calidad de vida de los animales de compañía y así, identificar de manera oportuna posibles enfermedades

Sorteo del Mundial 2026: día, hora y canal TV en Perú del evento de selecciones organizado por FIFA
La entidad rectora del fútbol mundial informó los detalles sobre el evento que determinará los rivales de las 48 selecciones participantes. El torneo se dará entre el 11 de junio y 19 de julio de 2026

Llovizna y frío en Lima: cuántos días durará la DANA ‘Qori’ y qué zonas serán las más afectadas, según Senamhi
Las persistentes lloviznas que cubren desde hace días a Lima, acompañadas por una humedad que roza el cien por ciento y temperaturas inusualmente bajas, tienen su causa en la presencia de la DANA ‘Qori’

Las contundentes razones por las que Alianza Lima fichará a Jairo Vélez: ¿por qué dejará Universitario?
Los ‘blanquiazules’ pagarán cláusula de salida por el jugador a César Vallejo, dueño de su pase. Está cerca de convertirse en nuevo fichaje de los victorianos




